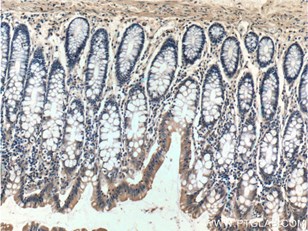

Metabolic Regulation of Cell Death
A matter of life and (cell) death...
Maintaining cellular energy balance is a key challenge for multicellular organisms. Nutrient availability and requirements are always in flux. At times, cells need to die for the health of the organism. The programming responsible for this sacrificial cell death is called “Apoptosis”. It is regulated by a host of factors, but the most important for energy balance are: mitochondria, AMPK/TORC1, Acetyl Coa, and the endoplasmic reticulum (ER).
Mitochondria are more than just the powerhouse of the cell. The permeability of the mitochondrial membrane plays a crucial role in metabolic control of apoptosis. Permeabilization of the outer membrane results in leakage of cytochrome c, which activates caspases and leads to apoptosis. This event is controlled metabolically by oxidative stress and the Bcl2 family of proteins (Figure 1), which are sensitive to protein synthesis rates and the activity of other metabolic players (1). Due to its apoptotic roles, Bcl2 mutations are implicated in autophagy process or cancers such as lymphoma (2 and 3).
 |
 |
|
Figure 1. Immunohistochemistry of paraffin-embedded human tonsillitis tissue slide using 12789-1-AP ( BCL2 Antibody) at dilution of 1:50 (under 40x lens) |
Immunohistochemical of paraffin-embedded human lung cancer using 12789-1-AP(BCL2 antibody) at dilution of 1:50 (under 40x lens) |
A set of key players, AMPK and TORC1, collaborate to regulate apoptosis. When glycolytic rates are low and the AMP: ATP ratio is high, AMPK inhibits TORC1, which in turn inhibits the rate of translation and promotes apoptosis (1). Interestingly, the cellular energy state of neurons in the hypothalamus can impact satiety of the organism (4).
Another important player, Acetyl-CoA, is produced and consumed during respiration. When the rate of consumption is higher than production, excess CoA activates CamKII, leading to caspase activation.
Besides these, the ER plays a crucial role in the metabolic control of cell death. To produce the variety of proteins in the cell, the ER requires amino acids, sugars, and oxygen. When these nutrients are missing, ER and Golgi processing of proteins slows down and the ER stress response is activated. During this process, PERK phosphorylates eIF2 Alpha (lowering translation rate) and activates pro-apoptotic transcription factors, tipping the scales further towards cell death. Usually, lowering translation rate is enough to improve the processing of proteins through the ER and Golgi apparatus, but, when it is not, apoptotic Bcl2 family members are activated and the mitochondrial route to apoptosis is started (Figure 2) (1).
 |
|
|
Figure 2. Immunofluorescent analysis of NIH/3T3 cells using 10783-1-AP( Bcl-xL Antibody) at dilution of 1:25 and Rhodamine-Goat anti-Rabbit IgG. |
Immunohistochemistry of paraffin-embedded human colon tissue slide using 10783-1-AP( Bcl-xL Antibody) at dilution of 1:200 (under 10x lens). |
ER stress is of particular importance to the pathogenesis of Diabetes (5) and many of the metabolic players above are mutated in cancer. Despite the numerous metabolic pathways to apoptosis, cancer finds ways to circumvent all of them. Discovering how we can activate these regulators again may lead to novel therapeutics for cancer.




